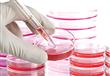

مساعد وزير الخارجية: نسبة الإصابة بالإيدز تزداد 40% كل عام
كتبت- مادي غيث:
طالب السفير محمود عامر، مساعد وزير الخارجية، بتعزيز سبل التعاون بين مصر والمنظمات الدولية؛ للعمل على القضاء على مرض الإيدز، من خلال العمل على زيادة أنشطة الدعم للمواطنين، بما يشمل الجانب الطبي والوقائي والعلاجي والدعم النفسي والاجتماعي، والقضاء على التمييز المرتبط بمرض الايدز.
وأضاف "عامر" خلال كلمته، بالاحتفال باليوم العالمي للإيدز، أن آخر الإحصائيات أثبتت أن هناك 11 ألف مصاب بمرض الإيدز من مختلف الأعمار في مصر، لافتا إلى أن النسبة تزداد بنسبة ٤٠٪ كل عام، وهذا يشكل عبئا على وزارة الصحة.
وأشار عامر إلى أن وزارة الخارجية على استعداد تام لتبني أي مبادرات تطرحها المنظمات؛ للقضاء على الأمراض التي تهدد مجتمعنا.